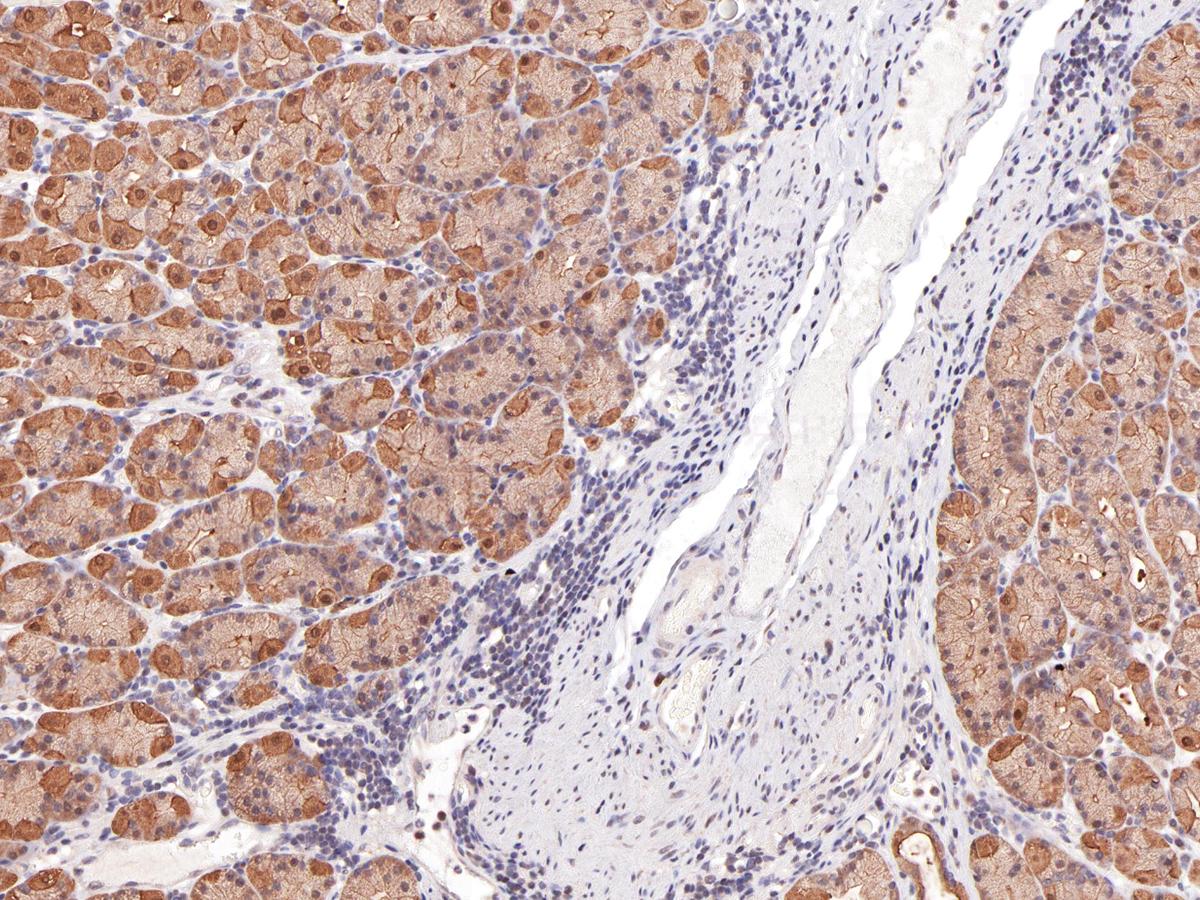

Anti-Survivin Monoclonal Antibody (Clone:IHC668)
Shipping Info:
For estimated delivery dates, please contact us at [email protected]
| Format : | Purified |
| Amount : | 1 ml |
| Purification : | Protein A/G Chromatography |
| Storage condition : | Store at 2°C - 8°C. |
Survivin is an apoptosis inhibitor that is nearly undetectable in terminally differentiated cells, but found in most tumors including renal cell carcinoma, ovarian carcinoma, hepatocellular carcinoma, prostate carcinoma and breast carcinoma. Survivin expression is linked to tumor progression, but not patient survival.
Recommended dilutions: Immunohistochemical analysis: 1:100 - 1:200. However, this need to be optimized based on the research applications.
For Research Use Only. Not for use in diagnostic/therapeutics procedures.
|
There are currently no product reviews
|

.png)










